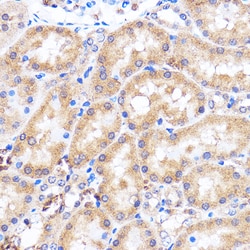
Invitrogen p38 MAPK alpha Polyclonal Antibody 100 &mu;L | Buy Online | Invitrogen&trade; | Fisher Scientific

missing translation for 'onlineSavingsMsg'
Learn More
Learn More
Invitrogen™ p38 MAPK alpha Polyclonal Antibody


Descripción
Positive test controls include: HeLa, BxPC-3, Mouse testis, Rat kidney. The target is usually found in the following locations: Cytoplasm, Nucleus.
MAPK14 (p38 alpha) is a member of the stress-activated protein kinase class of MAPKs. The p38 MAPK cascade regulates a variety of cellular responses to stress, inflammation, and other signals. p38 MAPK is relatively inactive in the nonphosphorylated form and becomes rapidly activated by dual phosphorylation of a Thr-Gly-Tyr motifs. There are four isoforms of p38 MAPK, which differ in their tissue expression and affinity for upstream activators and downstream effectors. When cells are exposed to tumor necrosis factor, interleukin-1, heat shock, or other activating stimuli, activation of MAPK kinase-3 occurs by phosphorylation. Activated MAPK kinase-3/6 phosphorylate each residue of Thr180 and Tyr182 in p38 MAPK. Phospho-p38 MAPK activates ATF-2, CHOP-1, MEF-2 and other transcription factors through phosphorylation.

Especificaciones
Especificaciones
| Antígeno | p38 MAPK alpha |
| Aplicaciones | ELISA, Immunohistochemistry (Paraffin), Immunoprecipitation, Western Blot, Immunocytochemistry |
| Clasificación | Polyclonal |
| Concentración | 1.65 mg/mL |
| Conjugado | Unconjugated |
| Formulación | PBS with 50% glycerol and 0.09% sodium azide; pH 7.3 |
| génica | MAPK14 |
| N.º de referencia del gen | P47811, P70618, Q16539 |
| Alias de gen | 186F5S; anon-sts23; BG:DS00797.3; CG7393; CG7393-PA; CRK1; CSAID-binding protein; Csaids binding protein; CSBP; Csbp1; Csbp2; CSPB1; cytokine suppressive anti-inflammatory drug binding protein; cytokine suppressive anti-inflammatory drug binding protein 1; cytokine suppressive anti-inflammatory drug-binding protein; cytokine-supressive anti-inflammatory drug binding protein; Dm p38b; Dmel\CG7393; Dmel_CG7393; Dmp38b; Dp38; D-p38; D-p38 MAPK; Dp38b; D-p38b; EC 2.7.11.24; ERK1; ERT2; ESTS:186F5S; etID18993.8; Exip; fk28c03; hm:zeh1243; Hog; I79_016605; LD24658p; MAP 14; MAP kinase 1; MAP kinase 11; MAP kinase 14; MAP kinase 14A; MAP kinase 2; MAP kinase Mxi2; MAP kinase p38; MAP kinase p38 alpha; MAP kinase p38 beta; MAP kinase p38a; MAP kinase p38alpha; MAP kinase p38b; MAPK; MAPK 11; MAPK 14; MAPK 14A; MAPK1 antibody; Mapk11; Mapk14; mapk14a; MAX-interacting protein 2; mitogen activated protein kinase 11; mitogen activated protein kinase 14; mitogen-activated protein kinase 11; Mitogen-activated protein kinase 14; mitogen-activated protein kinase 14a; Mitogen-activated protein kinase p38 alpha; mitogen-activated protein kinase p38 beta; mitogen-activated protein kinase p38-2; mitogen-activated protein kinase p38a; Mitogen-activated protein kinase p38b; MK14; Mpk34C; Mxi2; OTTHUMP00000216563; OTTHUMP00000216566; P38; p38 alpha; p38 alpha/Mxi2; p38 beta; p38 MAP kinase; p38 MAP kinase alpha; p38 MAPK; p38 mitogen activated protein kinase; p38 mitogen-activated protein kinase; p38-2; p38a; p38ALPHA; p38-alpha; p38alpha Exip; P38B; p38b MAP kinase; p38beta; p38beta2; p38b-PA; p38Hog; p38Kb; p38MAPK; PRKM11; Prkm14; Prkm15; protein kinase, mitogen activated kinase, 11, p38beta; reactive kinase; RK; RP1-179N16.5; Sapk2; Sapk2A; SAPK2b; stress-activated p38b MAP kinase; stress-activated protein kinase 2A; Stress-activated protein kinase 2b; stress-activated protein kinase-2; stress-activated protein kinase-2b; tRNA synthetase cofactor p38; wu:fk28c03; zeh1243; zp38a |
| Símbolos de los genes | MAPK14 |
| Mostrar más |
Título del producto
Al hacer clic en Enviar, acepta que Fisher Scientific se ponga en contacto con usted en relación con los comentarios que ha proporcionado en este formulario. No compartiremos su información para ningún otro fin. Toda la información de contacto proporcionada se mantendrá de acuerdo con nuestra Política de Privacidad. Política de privacidad.
¿Detecta una oportunidad de mejora?